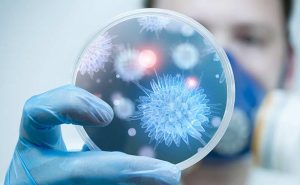
Ah Corona Virüsü Vah Corona Virüsü…

BÖLÜNÜP PARÇALANMA

Peygamberlerin en büyük mucizeleri, aralarında “tefrika” yâni “bölünüp parçalanma” olmamaları ve aynı davayı/tevhidi, aynı çerçevede savunmalarıdır. Bu gerçeklik Bakara/136. âyette şöyle anlatılır: “Deyin ki: Biz Allah’a inanırız; ve bize indirilene; ve İbrahim’e, İsmail’e, İshâk’a, Yakub’a ve onların soyundan gelenlere indirilene; ve Musa’ya, İsa’ya ve Rableri tarafından [diğer] tüm peygamberlere tevdî edilmiş olana [inanırız]; onların arasında hiçbir ayrım yapmayız. Ve biz O’na teslim olanlarız.”[1]Âyetin son kısmına dikkat edilirse peygamberlerin getirdiği bütün bu değişmeyen tek hakîkate inananlar “müslîm” olarak ifâde edilmiştir. Görülüyor ki; bu tevhidî bütünlüğe rağmen peygamberlere karşı çıkan veyâ sırt çeviren odaklar hep tefrika/bölünme üreticisi olmuşlardır. Bu bölünme, bir olan Allah’ın bir olan yolunu bölüp, birçok “yollar” ortaya çıkarmış ve insânı şaşırtıp perişan etmiştir. Allah bu konuda insânları şöyle uyarmaktadır: “Ve [bilin ki] bu, dosdoğru Bana yönelen bir yoldur: Öyleyse bunu izleyin ve diğer yollardan gitmeyin ki sizi O’nun yolundan saptırmasınlar. Allah [bütün] bunları size emretti ki O’na karşı sorumluluğunuzun bilincine varasınız.”[2]
Bu âyetler bir yandan geçmiş ümmetlerin bölünme/parçalanma/sürçme/batma nedenlerine ışık tutarken, diğer yandan da son peygamberin bağlılarının bu “tefrika” illetine yakalanmaması için birer uyarı niteliğindedir. Kur’ân bu noktada son vahyin temsilcilerine şöyle seslenir: “Hep birlikte Allah’ın ipine sımsıkı tutunun ve birbirinizden kopmayın. Ve Allah’ın size verdiği nimetleri hatırlayın: Siz birbirinize düşman iken kalplerinizi nasıl uzlaştırdı da O’nun lütfu ile kardeş oldunuz; ve ateşli bir uçurumun kenarında [iken] sizi ondan [nasıl] korudu. Bu şekilde Allah mesajlarını size açıklar ki hidayet bulasınız.”[3]
Aslında tartışma, parçalanma, bölünme, kamplara ayrılma insânın değişmez kaderidir ve bu, insân tekâmülünün de zorunlu şartıdır. Ancak bunun bir felâket hâlinde insânlığı kemirmemesi için bu farklılıkları tevhid potasında eritebilmek ve tüm insânlık için bir hayırda yarışa dönüştürmek lâzımdır. Çünkü insânlığın biyolojik orijininde “bir erkek ve bir kadından yaratılmış olmak” eşitliliği vardır ve sonradan kavimler ve kabileler hâline getirilişimizin tek nedeni de “birbirimizi tanıma” gerçeğine dayanmaktadır.[4]Yani, hepiniz birbirimiz üzerinde hiçbir kalıtımsal üstünlüğe sahip olmadan “tek bir insanlık ailesine” mensup olduğumuzu bilmeliyiz. Başka bir deyişle, insanların “kavimler ve kabileler”e dönüşmesi, görünürdeki farklılıklarının ardındaki temel insanî birliği/birlikteliği anlama ve takdir etme eğilimini azaltmayı değil, tersine bu eğilimi arttırmayı amaçlamaktadır.
Bu konuda bir başka âyette Mâide/48. âyettir: “…Biz, her biriniz için [farklı] bir sistem ve [farklı] bir hayat tarzı belirledik. Eğer Allah dileseydi, hepinizi bir tek topluluk yapardı: ama indirdikleri aracılığıyla sizi sınamak için [başka türlü diledi]. O halde hayırlı işlerde yarışın! Hepinizin dönüşü Allah’adır; o zaman Allah, ayrılığa düştüğünüz şeyleri size gösterecektir.”[5]
Âyette geçen Şir‘a yahut şerî‘a terimi, lafzî olarak, insanların ve hayvanların yaşamaları için zorunlu olan su ihtiyacını karşıladıkları “su kaynağına giden yol”u gösterir ve Kur’ân’da bir topluluğun sosyal ve mânevî refahı için gerekli olan bir hukuk sistemini göstermek için kullanılır. Diğer taraftan minhâc terimi, genellikle soyut anlam taşıyan “açık yol”, yani bir “hayat biçimi” anlamına gelir. Ancak, şir‘a ve minhâc terimleri, yalnızca belli bir inanç sistemi ile ilgili kanunları değil ama aynı zamanda Kur’ân’a göre Allah’ın her peygamberi tarafından tebliğ edilen bütün değişmez, temel mânevî hakikatleri de kapsayan dîn teriminden anlam olarak daha dar kapsamlıdır. Çünkü Peygamberler tarafından tesis edilen belli bir hukuk sistemi –şir‘a veya şerî’a– ve tavsiye edilen hayat biçimi –minhâc-, zamanın ihtiyaçlarına ve her toplumun kültürel gelişmesine bağlı olarak değişir. İşte bu “çoklukta birlik” Kur’ân’da sıkça vurgulanmıştır.[6] Bütün bunlar Allah’a inanan müslim ve gayrimüslim herkese, dinî uygulamalarındaki farklılıkların, onları karşılıklı düşmanlığa sürüklemek yerine “hayırlı işlerde birbirleriyle yarışma”ya yöneltmesi gerektiğini vurgulamaktadır.
Ama ne var ki; bu ilâhî uyarılara rağmen yaşanan gerçek farklı olmuştur. Yahudiler, peygamberliğin yalnız İsrailoğulları’na bahşedilen bir imtiyaz olduğuna inanırken Hristiyanlar da, Hz. Îsâ’nın –ki o da İsrailoğulları soyundan gelen biriydi– Allah’ın yeryüzündeki nihaî tezahürü olduğunu iddia etmişler ve bu iki zümreden her biri de kurtuluşun yalnızca kendi mensuplarına özgü olduğunu ileri sürmüşlerdir.[7] Buna mukabil Kur’an, Allah’ın bütün insanlığın Rabbi olduğunu ve her ferdin yalnızca kendi inançlarına ve davranışlarına bakılarak yargılanacağını vurgulamak suretiyle bu fikirleri reddetmiştir.
Şimdi İslâm dünyasına baktığımızda Kur’ân’ın onaylamadığı bu bölünmenin/parçalanmanın Müslümanlar arasında da neredeyse kemikleşmiş bir yapıya dönüştüğünün görmemiz mümkündür. Aynı Allah’a, aynı peygambere, aynı kitaba inandıklarını söyleyen bu insânların “ırki/etnik asabiyat” bir yana çeşitli mezhep, meşrep, mizaç, cemaat, fırka, parti gibi çeşitli sosyal gruplara ayrılması ve her grubun da “gerçeği yalnız kendisinin temsil ettiğini” düşünmesi, ne yazık ki İslâm ve iman kardeşliğinin önüne geçmiştir. Kur’ân’a göre tehlikeli bir gelişme olan bu tefrika/bölünme eğer önüne geçilmezse şirke kadar yol açan bir eyleme dönüşebilir. Rum/30-32. âyetleri bu tehlikenin boyutlarını bize şöyle göstermektedir:
“Böylece sen, bâtıl olan her şeyden uzaklaşarak yüzünü kararlı bir şekilde [hak olan] dine çevir ve Allah’ın insân bünyesine nakşettiği fıtrata uygun davran:[ki,] Allah’ın yarattığında bir bozulma ve çürümeye meydan verilmesin: bu, sahih [bir] din[in gayesi]dir; ama çoğu insanlar onu bilmezler.”[8]
“[O halde bâtıl olan her şeyden yüz çevirerek yalnızca] O’na yönel; ve O’na karşı sorumluluğunun bilincinde ol; namazını devamlı ve dikkatli şekilde ifa et ve O’ndan başkasına ilâhlık yakıştıranlar arasına girme.”[9]
“[Yahut] inançlarının bütünlüğünü bozarak parçalara bölünen ve her grubun yalnız kendi sahip olduğu [ilkelerle] övündüğü kimselerden olma!”[10]
İslâm dünyasında Hz. Peygamber sonrası ortaya çıkan tartışma ve çekişmelerin büyük bir kısmı, ilâhî vahyin yorumlanmasındaki görüş ve anlayış farklılıklarından doğmuştur. Çünkü Kur’ân, insânlığın yalnız o günkü boyutlarına ışık ve açıklık getirmemekte, ileriki zamanların çeşitli tekâmül aşamalarına da çözümler sunmaktadır. Böylesine çok boyutlu bir kelâmın, ümmet içerisinde sayısız fikirlerin ortaya atılmasına zemin hazırlaması şüphesiz kaçınılmazdır. Bu tartışmaları bir yanı ile kelâmın zenginliğine ve bu konudaki “ihtilafın rahmet oluşuna” bağlamak mümkündür. Ama bu tartışma ve çekişmeleri, “düşmanlık, kavga, kin, tekfir, fitne” boyutuna getirmek, dünya ve mevki hırsına alet etmek tefrika ve parçalanmanın temel nedenlerinden biridir. Bu da tarih boyunca bize göstermiştir ki; Müslüman kuşakların ana problemi tefrika olmuştur ve en önemlisi onları perişan eden felâket dıştan değil, içten gelmiştir.
Kısaca: Kendi ülkesini “lider ülke”, kendi milletini “Allah’ın seçtiği kurtulmuş millet” olarak gören, önderi olduğu fıkıhçıların vermiş oldukları fetvâlara aykırı düşen âyetlerin “mensuh” ve “tevile muhtaç” olduğunu düşünen, yine kendi mezhep müctehitlerinin yaptıkları içtihatları tartışılmaz kesin doğrular olarak kabul eden, hattâ Hz. Peygamber’in bile kendi mezheplerinden olduğunu savunan, içinde bulundukları meşreplerini/tarikatlerını insânî/ruhânî yükselişi sağlayan bir sevgi, merhamet, ferâgat, irfân ve hizmet kurumu olmaktan çıkarıp, karşı meşrepteki kardeşlerinin kusurunu arama, kötü zan, gıybet, dedikodu, fitne, kin, çıkar, ideoloi, güç kurumuna dönüştüren bir inancın fertlerinin tevhide ne kadar bağlı oldukları üzerinde düşünülmelidir. Ülfet ne kadar erdirici ve mutlu edici ise tefrika/bölünme/parçalanma/fırkalaşma da o kadar zedeleyici ve yıkıcıdır. Kur’ân’ın rûhunda tevhid yattığına göre bölünme/parçalanma Kur’ân’a ve Hz. Peygamber’e ihânet olarak değerlendirilebilir.
NECMETTİN ŞAHİNLER
MİRATHABER.COM -YOUTUBE-
YAZARIN DİĞER YAZILARINA ULAŞMAK İÇİN BURAYA TIKLAYINIZ
[1] Bakara/136 “Kûlû âmennâ billâhi ve mâ unzile ileynâ ve mâ unzile ilâ ibrâhîme ve ismâîle ve ishâka ve ya’kûbe vel esbâtı ve mâ ûtiye mûsâ ve îsâ ve mâ ûtiyen nebiyyûne min rabbihim, lâ nuferriku beyne ehadin minhum ve nahnu lehu muslimûn(muslimûne).”
[2] En’âm/153 “Ve enne hâzâ sırâtî mustekîmen fettebiûh(fettebiûhu), ve lâ tettebiûs subule fe teferreka bikum an sebîlih(sebîlihi), zâlikum vassâkum bihî leallekum tettekûn(tettekûne).”
[3] Âl-i İmrân/103 “Va’tasımû bihablillâhi cemîân ve lâ teferrekû, vezkurû ni’metallâhi aleykum iz kuntum a’dâen fe ellefe beyne kulûbikum fe asbahtum bi ni’metihî ihvânâ(ihvânen), ve kuntum alâ şefâ hufretin minen nâri fe enkazekum minhâ, kezâlike yubeyyinullâhu lekum âyâtihî leallekum tehtedûn(tehtedûne).”
[4] Hucurat/13
[5] Mâide/48 “…li kullin cealnâ minkum şir’aten ve minhâcâ(minhâcen) ve lev şâallâhu le cealekum ummeten vâhıdeten ve lâkin li yebluvekum fî mâ âtâkum festebikûl hayrât(hayrâti) ilâllâhi merciukum cemîan fe yunebbiukum bimâ kuntum fîhi tahtelifûn(tahtelifûne).”
[6] Bakara/148; Enbiya/92-93; Müminun/52-53
[7] Bakara/111, 135
[8] Rum/30 “Fe ekim vecheke lid dîni hanîfâ(hanîfen), fıtratallâhilletî fataran nâse aleyhâ, lâ tebdîle li halkıllâh(halkıllâhi), zâliked dînul kayyimu ve lâkinne ekseren nâsi lâ ya’lemûn(ya’lemûne).”
[9] Rum/31 “Munîbîne ileyhi vettekûhu ve ekîmûs salâte ve lâ tekûnû minel muşrikîn(muşrikîne).”
[10] Rum/32 “Minellezîne ferrakû dînehum ve kânû şiyeâ(şiyean), kullu hızbin bimâ ledeyhim ferihûn(ferihûne).”

İnsanlığın ihtiyaç duyduğu ibret alınası cümleler 🌷